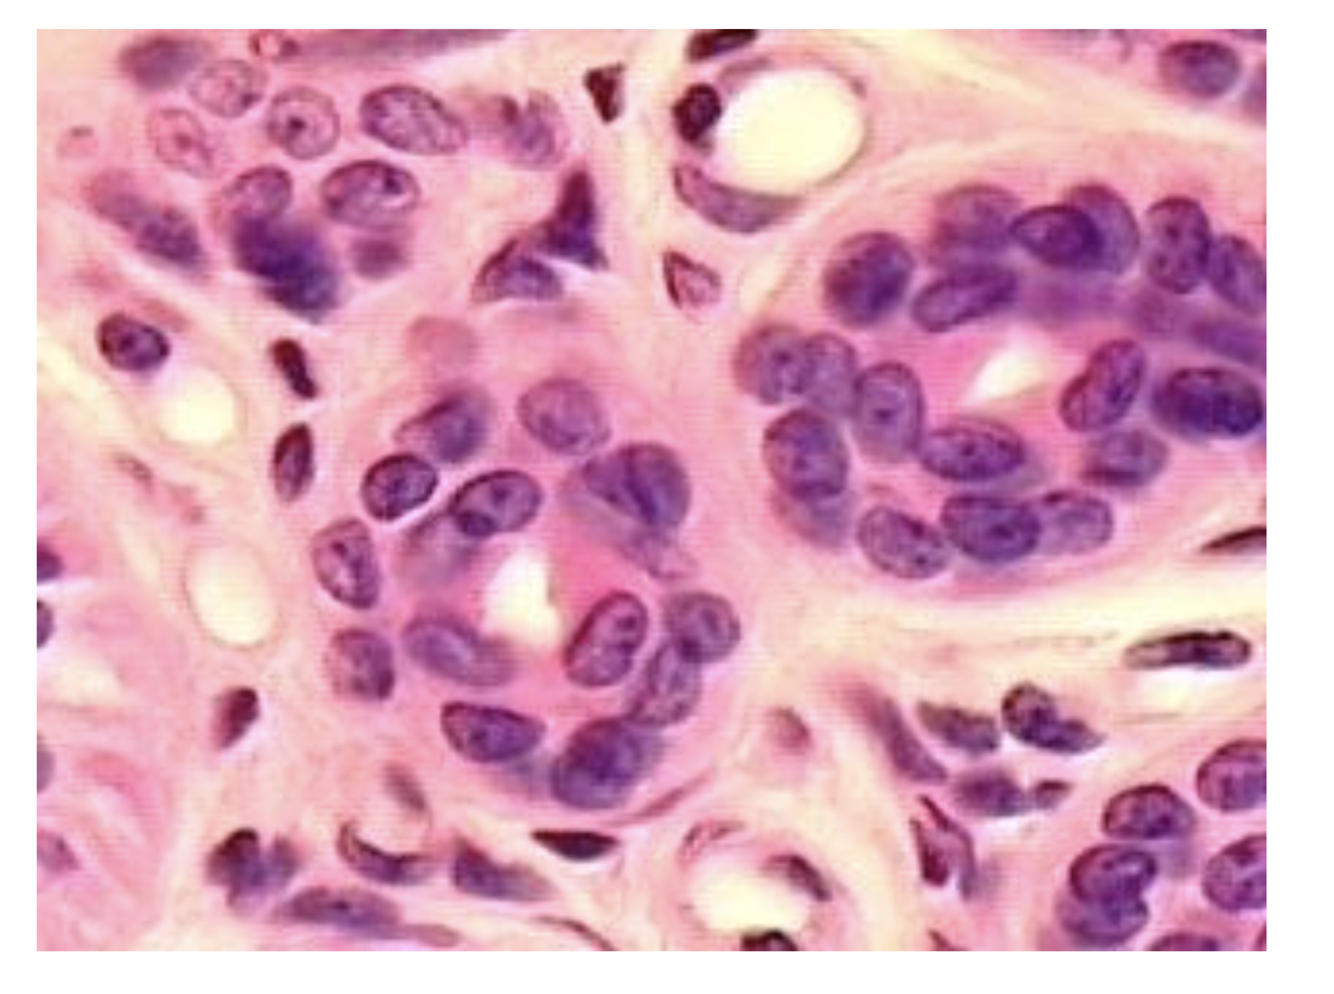

Epithelial Cells

Simple Columnar

Stratified Cuboidal

Simple Cuboidal

Endocrine Gland

Transitional

Microvilli
Stratified Cuboidal

Stratified Squamous

Exocrine Gland

Stratified Columnar

Simple Squamous

Glands

Exocrine Gland

Stratified Columnar

Tight Junctions

Desmosomes

Cilia

Adherent Junctions

Desmosomes

Simple Columnar

Transitional

Simple Squamous